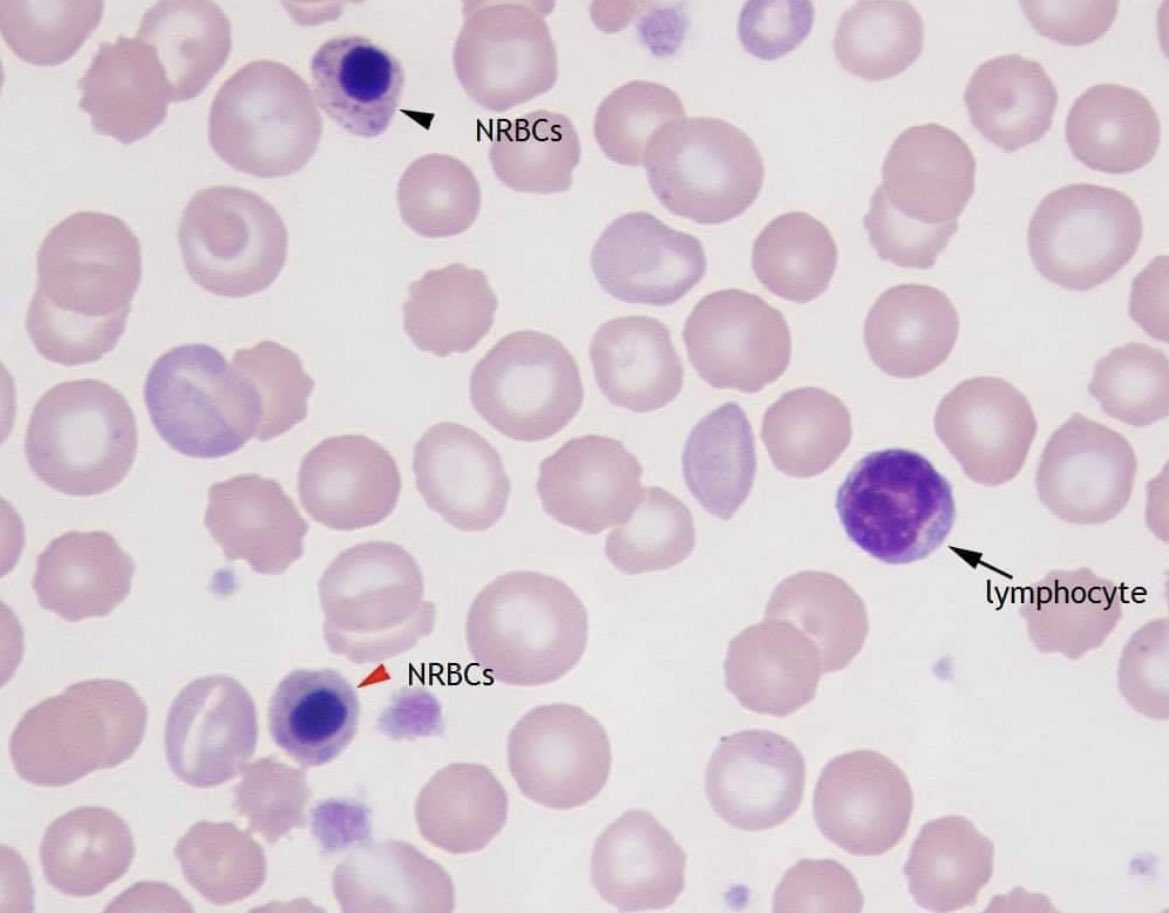
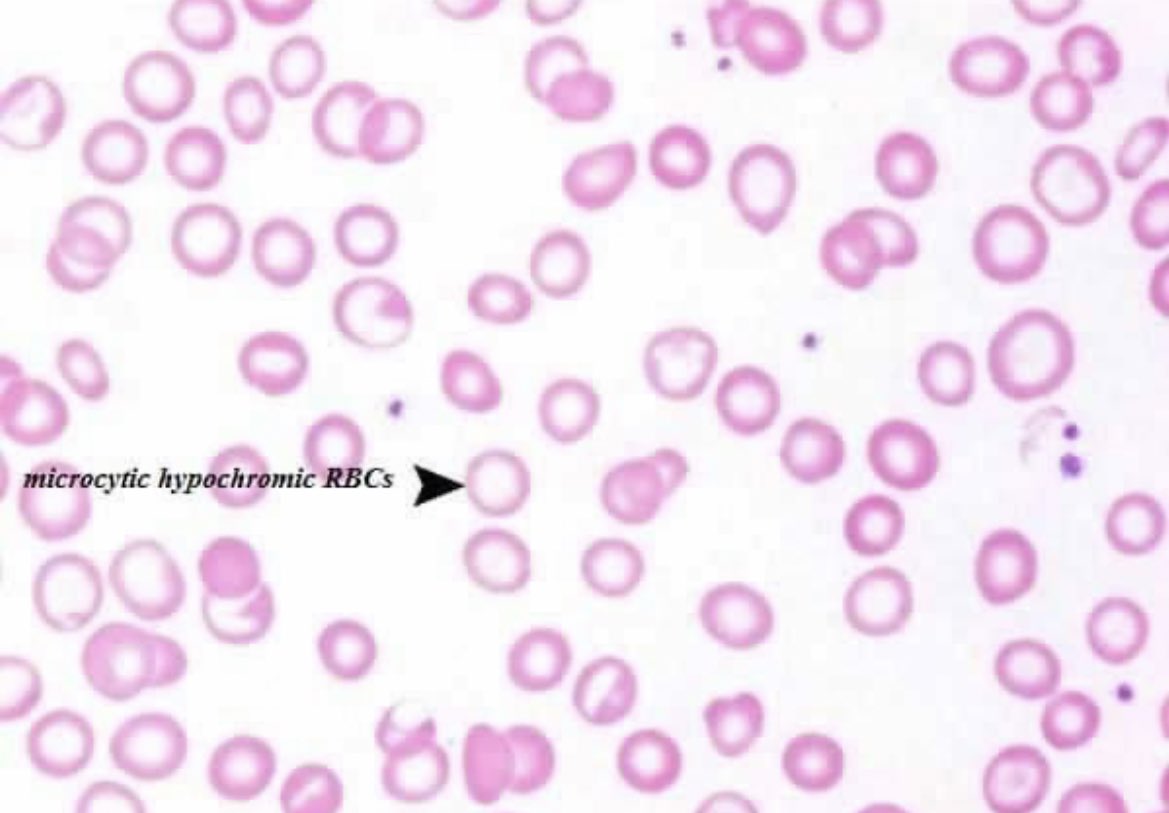
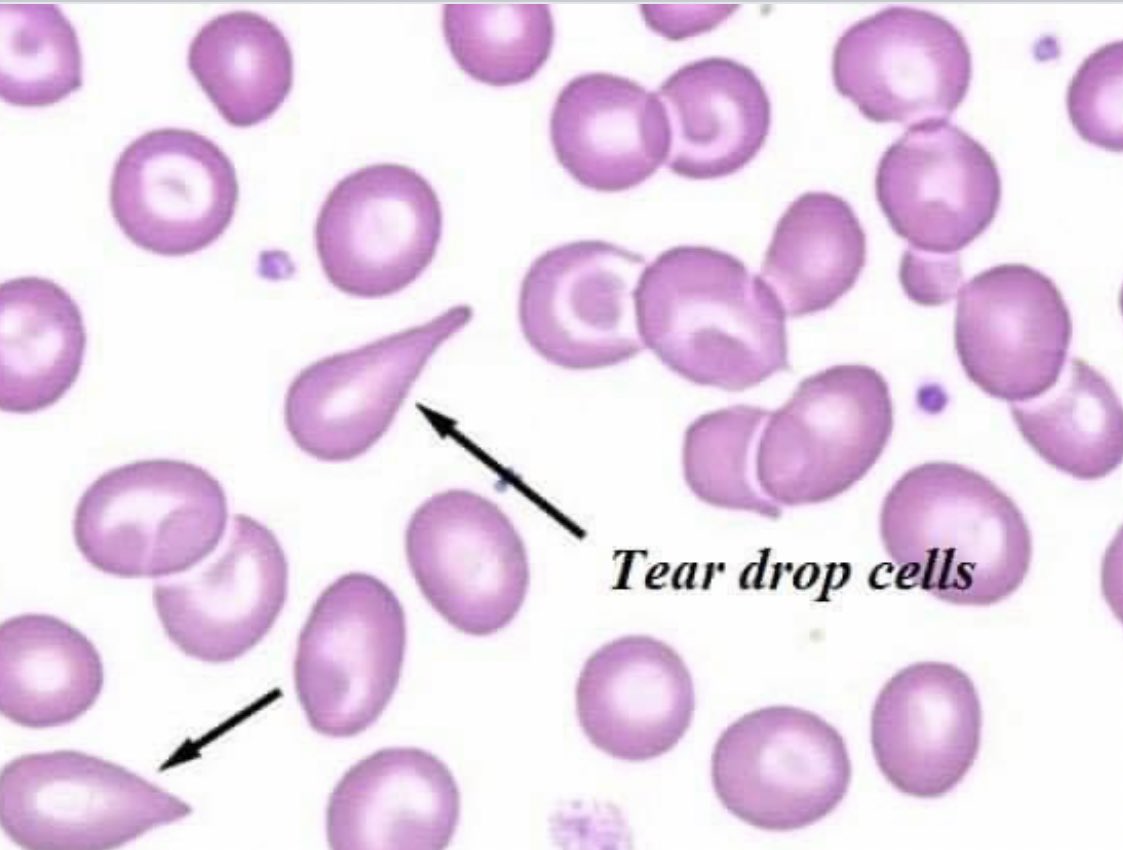
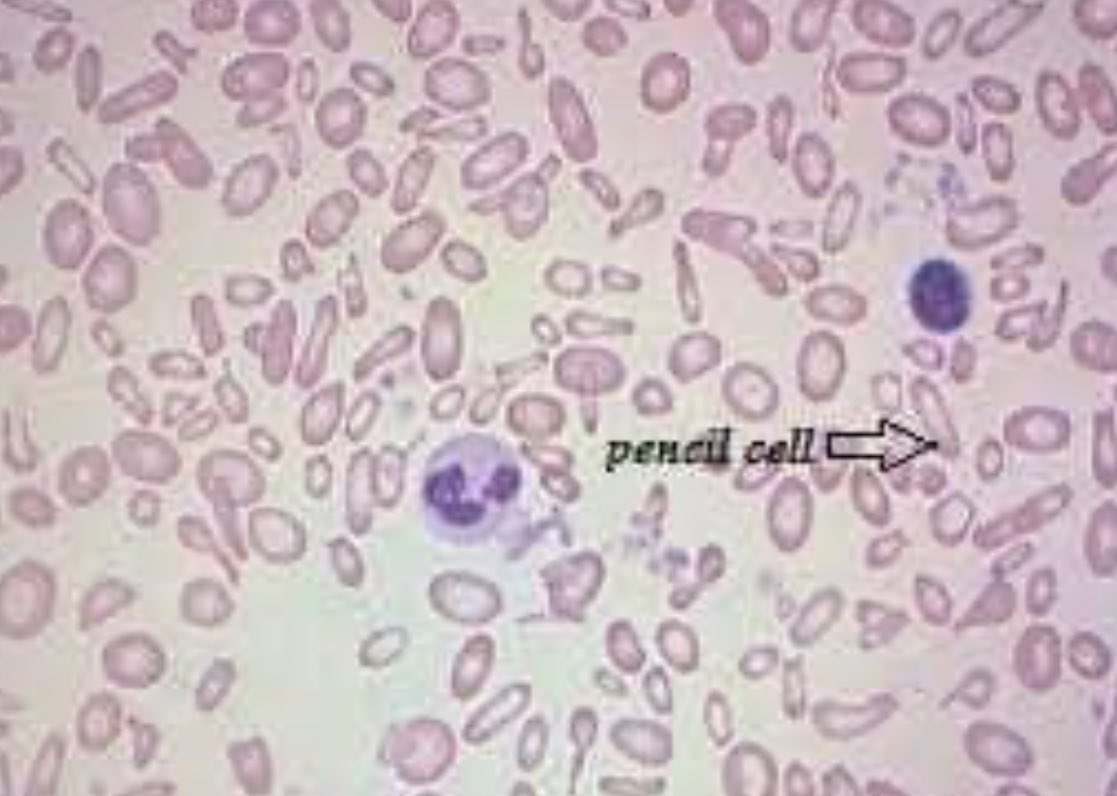

🩸اول شي راح نشوف قيمة Serum ferritinقليلة جدا
"ملحوظة"
لازم تنتبه ان هذا الاختبار غير حساس في حالات الالتهابات بمعنى لو كان المريض عنده التهاب ممكن تكون النتيجهة طبيعية جدا وهو عنده انيميا عادي
🩸ايضا بنلاحظ قيمة Serum iron منخفضة جدا
"ملحوظة"
لازم تنتبه ان هذا الاختبار غير حساس في حالات الالتهابات بمعنى لو كان المريض عنده التهاب ممكن تكون النتيجهة طبيعية جدا وهو عنده انيميا عادي
🩸ايضا بنلاحظ قيمة Serum iron منخفضة جدا
🩸ايضا قيمة Total iron binding capacity تكون جدا عالية
🩸بنلاحظ كمان قيمة transferrin saturationبتكون اقل من 10%
🩸بنلاحظ ارتفاع قيمة Free erythrocyte protoporphyrin وهذا يعتبر مؤشر مبكر جدا لنقص مستوى الحديد الناتج عن سوء التغذيه
🩸بنلاحظ كمان قيمة transferrin saturationبتكون اقل من 10%
🩸بنلاحظ ارتفاع قيمة Free erythrocyte protoporphyrin وهذا يعتبر مؤشر مبكر جدا لنقص مستوى الحديد الناتج عن سوء التغذيه
🩸اخيرا ارتفاع قيمة soluble transferrin receptor (sTfR
جاري تحميل الاقتراحات...